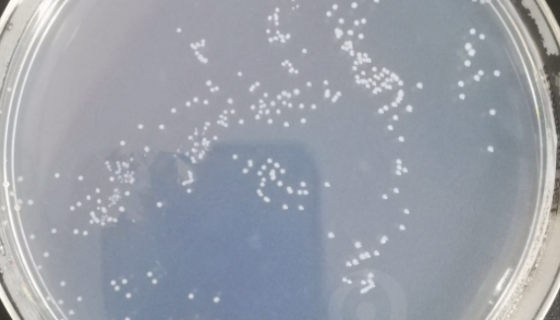
热紫链霉菌不渗透亚种ATCC 19994知识解析！
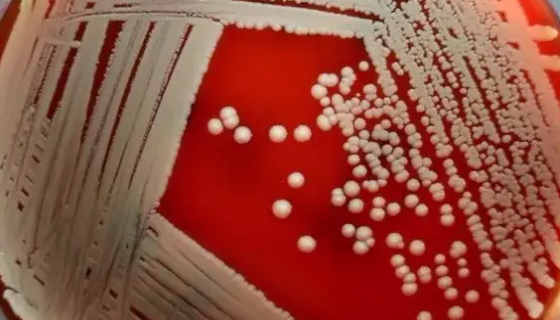
溶血葡萄球菌的致病物质与免疫性质及鉴别要点！
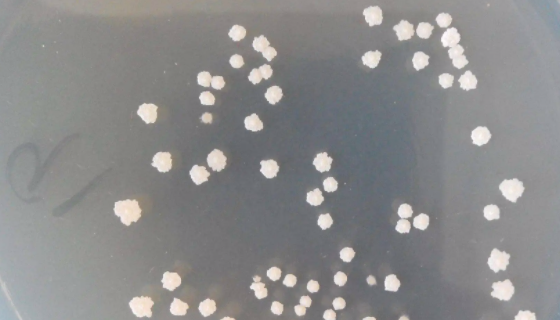
嗜热淀粉芽孢杆菌的形态特征与主要价值！

热紫链霉菌不渗透亚种ATCC 19994知识解析!
热紫链霉菌不渗透亚种,气丝灰色。基丝中等。甘油天冬素琼脂:气...
溶血葡萄球菌的致病物质与免疫性质及鉴别要点!
溶血葡萄球菌是一群革兰氏阳性球菌,因常堆聚成葡萄串状,故名。...

植物乳杆菌的生理功能及其发展与研究!
植物乳杆菌是乳杆菌科中的一种乳杆菌属,菌种形态为直或弯曲杆状...
嗜热淀粉芽孢杆菌的形态特征与主要价值!
嗜热淀粉芽孢杆菌是Bacillus属的微生物,原产地为中国。...

ATCC 8664 浅紫灰链霉菌浅紫灰亚种知识解析!
浅紫灰链霉菌浅紫灰亚种是Streptomyces属的微生物,...

有益微生物菌消失了,如何失而复得?
工业化彻底改变了我们的生活,从饮食到治疗方式。而这些变化也在...

木醋杆菌的生产环境与培养条件及主要用途!
木醋杆菌,醋杆菌属(学名:Acetobacter)是乙酸细菌...

肉毒梭菌的涉及型式与生存分布及致病机理!
肉毒梭菌一般指肉毒杆菌,是一种生长在缺氧环境下的细菌,在罐头...

人肺泡上皮细胞的背景与概述及相关研究!
人肺泡上皮细胞由肺泡I型和Ⅱ型上皮细胞组成,线性分布于肺内9...